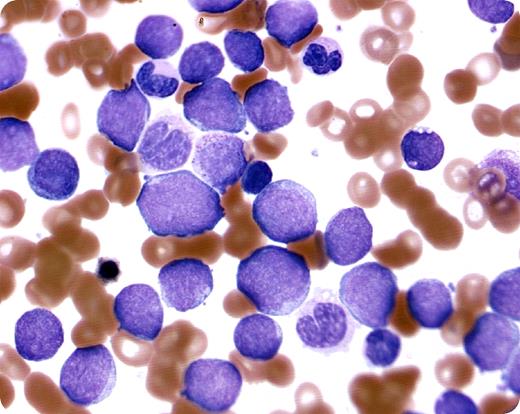
A 62-year-old woman was seen in the emergency room for fatigue. On examination, she was found to have lymphadenopathy affecting the anterior cervical, axillary, and inguinal areas. She also had non-tender hepatosplenomegaly. Complete blood count revealed a hemoglobin of 76 g/L, platelets 99 × 109/L, and severe leukocytosis (297 × 109/L). The differential showed 90% blasts (blood smear shown). / The peripheral smear and the bone marrow blasts were intermediate to large in size, with some prominent nucleoli; 10% were myeloperoxidase positive. Myeloid maturation was also present in a few blasts. Flow cytometry affirmed an abnormal immature myeloid population. Probes for BCR-ABL were negative. / The patient received emergent leukopheresis in the emergency room. A diagnosis of blast crises secondary to acute myeloid leukemia without maturation (French-American-British classification AML-M1) was made. She was started on chemotherapy, initially with Ara-C and mitoxantrone, and later switched to decitabine. The patient responded well to the treatment.

A 62-year-old woman was seen in the emergency room for fatigue. On examination, she was found to have lymphadenopathy affecting the anterior cervical, axillary, and inguinal areas. She also had non-tender hepatosplenomegaly. Complete blood count revealed a hemoglobin of 76 g/L, platelets 99 × 109/L, and severe leukocytosis (297 × 109/L). The differential showed 90% blasts (blood smear shown).
The peripheral smear and the bone marrow blasts were intermediate to large in size, with some prominent nucleoli; 10% were myeloperoxidase positive. Myeloid maturation was also present in a few blasts. Flow cytometry affirmed an abnormal immature myeloid population. Probes for BCR-ABL were negative.
The patient received emergent leukopheresis in the emergency room. A diagnosis of blast crises secondary to acute myeloid leukemia without maturation (French-American-British classification AML-M1) was made. She was started on chemotherapy, initially with Ara-C and mitoxantrone, and later switched to decitabine. The patient responded well to the treatment.
A 62-year-old woman was seen in the emergency room for fatigue. On examination, she was found to have lymphadenopathy affecting the anterior cervical, axillary, and inguinal areas. She also had non-tender hepatosplenomegaly. Complete blood count revealed a hemoglobin of 76 g/L, platelets 99 × 109/L, and severe leukocytosis (297 × 109/L). The differential showed 90% blasts (blood smear shown).
The peripheral smear and the bone marrow blasts were intermediate to large in size, with some prominent nucleoli; 10% were myeloperoxidase positive. Myeloid maturation was also present in a few blasts. Flow cytometry affirmed an abnormal immature myeloid population. Probes for BCR-ABL were negative.
The patient received emergent leukopheresis in the emergency room. A diagnosis of blast crises secondary to acute myeloid leukemia without maturation (French-American-British classification AML-M1) was made. She was started on chemotherapy, initially with Ara-C and mitoxantrone, and later switched to decitabine. The patient responded well to the treatment.
Many Blood Work images are provided by the ASH IMAGE BANK, a reference and teaching tool that is continually updated with new atlas images and images of case studies. For more information or to contribute to the Image Bank, visit www.ashimagebank.org.
This feature is available to Subscribers Only
Sign In or Create an Account Close Modal